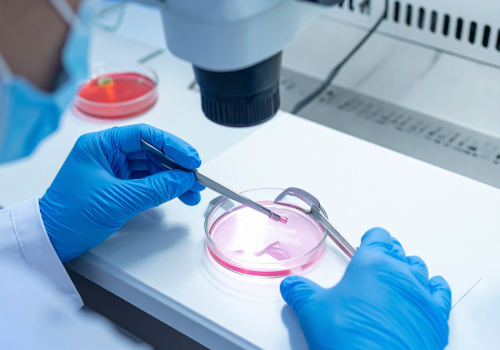
2

Services
- Home
- Services
- What We Provide
Our Popular Logistics Services

Customs Clearing Services
We provide complete customs clearance solutions for both import and export shipments. Our experienced team manages all documentation, assessments, and coordination with customs, airlines, and port authorities to ensure fast release and compliance. Using advanced RES systems for electronic filing, we eliminate delays and errors. Whether for air, sea, or ICD operations, we ensure transparency, efficiency, and accuracy—making customs procedures seamless and stress-free for all our clients.

Freight Forwarding & Cargo Consolidation
Our freight forwarding services connect your business to global markets through reliable air and sea freight solutions. We manage LCL and FCL consolidation, carrier bookings, documentation, and tracking, ensuring cost efficiency and timely delivery. Through our extensive global network, we guarantee secure and streamlined transportation of goods. Our team’s expertise ensures your cargo moves smoothly from origin to destination while keeping you informed at every stage.

Road Freight
We offer nationwide road transport services designed for reliability, speed, and safety. From industrial materials to consumer goods, we handle all types of cargo using GPS-enabled vehicles and trusted logistics partners. Our dedicated drivers and operational control team ensure on-time delivery across India. With flexible options for part and full truckloads, we provide an efficient road network that supports your business supply chain seamlessly.

Air Freight
Our air freight division provides rapid and secure global transportation for time-sensitive shipments. We manage everything from cargo booking and documentation to clearance and final delivery. Through direct coordination with major airlines, we ensure priority handling and faster transit times. Our advanced tracking system keeps you updated throughout the journey, offering reliability and control. Whether high-value goods or urgent consignments, we guarantee speed and precision in every shipment.

Ocean Freight
We provide comprehensive ocean freight services that balance cost efficiency with global reach. Our strong relationships with leading shipping lines allow us to offer flexible FCL and LCL options. We handle documentation, port coordination, and tracking to ensure smooth movement of goods worldwide. Every consignment is managed with attention to detail, ensuring on-time departures and safe arrivals while optimizing logistics costs for our clients.

Project Logistics
We handle specialized logistics for oversized, heavy-lift, or time-critical cargo through customized project management. From planning routes to obtaining permissions and coordinating multimodal transport, we ensure flawless execution. Our expert team works closely with clients, ports, and local authorities to deliver large-scale industrial and infrastructure cargo safely. With technical expertise and precision handling, we provide reliable solutions for the most complex logistics challenges.

Customs Brokerage
We offer professional customs brokerage services to simplify the import and export process. Our licensed brokers manage document preparation, classification, valuation, and duty assessment in line with Indian regulations. By maintaining close coordination with customs officials, we ensure faster processing and clearance. With a focus on accuracy, compliance, and speed, our brokerage team guarantees a smooth experience, avoiding unnecessary penalties and delays for every shipment.

Inland Waterways Transport
Our inland waterways transport service provides a sustainable and cost-effective logistics alternative. Ideal for bulk and containerized cargo, it ensures smooth connectivity between ports and industrial hubs. By integrating waterways with road and rail, we create efficient multimodal logistics chains. Our operations minimize congestion, reduce carbon emissions, and lower costs—offering businesses an eco-friendly way to move large volumes of goods across India’s river routes.

Warehousing & Transportation
We offer modern, secure warehousing solutions strategically located near airports and ICDs. Our facilities are designed to handle diverse cargo types, including temperature-sensitive and high-value goods. With a pre-deposit system to avoid clearance delays, we guarantee smooth operations. Combined with our dedicated fleet, we ensure fast and reliable door-to-door cargo delivery. Every consignment is tracked and handled carefully, ensuring complete safety and efficiency.
Perishable & Medical Cargo Handling
We specialize in handling perishable and temperature-controlled cargo, including pharmaceuticals, diagnostics, and food-grade shipments. Our trained team ensures fast customs clearance, temperature integrity, and regulatory compliance. With dedicated cold-chain systems and 24/7 monitoring, we minimize transit time and maintain product quality. Every step—from arrival to delivery—is managed with precision to preserve freshness and value, making us a trusted name in sensitive cargo management.

Import & Export Consultancy
Our consultancy services help businesses optimize their import and export operations. We provide guidance on HS codes, duty structures, documentation, exemptions, and regulatory compliance. With deep expertise in trade procedures, we assist clients in reducing operational costs and avoiding legal complications. Our insights into customs and DGFT policies ensure that your business stays compliant, efficient, and competitive in an ever-evolving international trade environment.
- Contact
Get in touch with us
At Anand Agencies (India), we believe communication is the foundation of efficient logistics. Please feel free to reach out to us through the contact details below or simply fill out the inquiry form.
- Anand Agencies (India) Licensed Customs Clearing, Shipping & Freight Forwarding Company
- Head Office: 104 Anupam Plaza 2 DDA LSC Ghazipur East Delhi 110096 INDIA
- Branch Office: 111 Vardhman Master Plaza DDA LSC Ghazipur East Delhi 110096
- UP Office: H-905 RESIDENCY RAJNAGAR EXTENSION GHAZIABAD UTTAR PRADESH 201017
- +91 9999095678, +91 8076952902, +91 9810321789, 011-43067482
- info@anandagenciesindia.in
